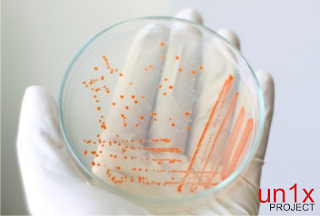

100 Orang PALING PINTAR Dengan IQ TERTINGGI Di Dunia | Un1x Project | Berikut Daftar Adalah orang orang yang memiliki kecerdasan tertinggi di dunia yang dilihat dari tingkat IQ nya. Beberapa diantaranya adalah Ilmuan ternama Dan Tokoh Terkenal dunia. Kebanyakan mereka telah meninggal dan ada juga yang masih hidup sampai saat ini seperti Pak BJ.Habibie yang juga merupakan muslim dengan IQ tertinggi di dunia seperti artikel sebelumnya yang telah munsypedia bahas..
Dan Berikut Adalah 100 Diantaranya..
1.Leonardo da Vinci Universal Genius,asal Italy, IQ 220
2.Johann Wolfgang von Goethe — Germany 210
3.Gottfried Wilhelm von Leibniz — Germany 205
4.Emanuel Swedenborg — Sweden 205
5.William James Sidis — USA 250
6.Kim Ung-Yong — Korea 210
7.BJ.Habibie — Indonesia 200
8.Hugo Grotius Writer Holland 200
9.Sir Francis Galton Scientist & doctor England 200
10.John Stuart Mill Universal Genius England 200
11.Christopher Langan Bouncer & scientist & philosopher USA 195
12.Sarpi Councilor & theologian & historian Italy 195
13.George H. Choueiri A.C.E Leader Lebanon 195
14.Blaise Pascal Mathematician & religious philosopher France 195
15.Ludwig Wittgenstein Philosopher Austria 190
16.Phillipp Melanchthon Humanist & theologian Germany 190
17.PierreSimon de Laplace Astronomer & mathematician France 190
18.Philip Emeagwali Mathematician Nigeria 190
19.William Pitt (the Younger) Politician England 190
20.Voltaire Writer France 190
21.Albrecht von Haller Medical scientist Switzerland 190
22.George Berkeley Philosopher Ireland 190
23.Garry Kasparov Chess player Russia 190
24.Sir Isaac Newton Scientist England 190
25.Friedrich von Schelling Philosopher Germany 190
26.Arnauld Theologian France 190
27.Bobby Fischer Chess player USA 187
28.Marilyn vos Savant Writer USA 186
29.Galileo Galilei Physicist & astronomer & philosopher Italy 185
30.Joseph Louis Lagrange Mathematician & astronomer Italy/France 185
31.Ren Descartes Mathematician & philosopher France 185
32.Lord Byron Poet & writer England 180
33.David Hume Philosopher & politician Scotland 180
34.John H. Sununu Chief of Staff for President Bush USA 180
35.James Woods Actor USA 180
36.Madame de Stael Novelist & philosopher France 180
37.Charles Dickens Writer England 180
38.Thomas Chatterton Poet & writer England 180
39.Alexander Pope Poet & writer England 180
40.Buonarroti Michelangelo Artist, poet & architect Italy 180
41.Benjamin Netanyahu Israeli Prime Minister Israel 180
42.Arne Beurling Mathematician Sweden 180
43.Baruch Spinoza Philosopher Holland 175
44.Johannes Kepler Mathematician, physicist & astronomer Germany 175
45.Immanuel Kant Philosopher Germany 175
46.Robert Byrne Chess Player Irland 170
47.Johann Strauss Composer Germany 170
48.Hypatia Philosopher & mathematician Alexandria 170
49.Richard Wagner Composer Germany 170
50.Andrew J. Wiles Mathematician England 170
51.Sofia Kovalevskaya Mathematician & writer Sweden/Russia 170
52.Dr David Livingstone Explorer & doctor Scotland 170
53.Donald Byrne Chess Player Irland 170
54.Martin Luther Theorist Germany 170
55.Judith Polgar Chess player Hungary 170
56.Plato Philosopher Greece 170
57.George Friedrich H?ndel Composer Germany 170
58.Raphael Artist Italy 170
59.Felix Mendelssohn Composer Germany 165
60.Truman Cloak — – 165
61.JohnLocke Philosopher England 165
62.Ludwig van Beethoven Composer Germany 165
63.Charles Darwin Naturalist England 165
64.Carl von Linn Botanist Sweden 165
65.Johann Sebastian Bach Composer Germany 165
66.James Watt Physicist & technician Scotland 165
67.Friedrich Hegel Philosopher Germany 165
68.Wolfgang Amadeus Mozart Composer Austria 165
69.Jola Sigmond Teacher Sweden 161
70.Dolph Lundgren Actor Sweden 160
71.Bill Gates CEO, Microsoft USA 160
72.Albert Einstein Physicist USA 160
73.George Eliot (Mary Ann Evans) Writer England 160
74.Paul Allen Microsoft cofounder USA 160
75.Nicolaus Copernicus Astronomer Poland 160
76.Joseph Haydn Composer Austria 160
77.Benjamin Franklin Writer, scientist & politician USA 160
78.James Cook Explorer England 160
79.Stephen W. Hawking Physicist England 160
80.Sir Clive Sinclair Inventor England 159
81.Honor de Balzac Writer France 155
82.Anthonis van Dyck Artist Belgium 155
83.Miguel de Cervantes Writer Spain 155
84.Ralph Waldo Emerson Writer USA 155
85.Rembrandt van Rijn Artist Holland 155
86.Jonathan Swift Writer & theologian England 155
87.Sharon Stone Actress USA 154
88.John Quincy Adams President USA 153
89.George Sand Writer France 150
90.Rousseau Writer France 150
91.Jayne Mansfield — USA 149
92.H. C. Anderson Writer Denmark 145
93.Bonaparte Napoleon Emperor France 145
94.Richard Nixon Ex-President USA 143
95.Hjalmar Schacht Nazi officer Germany 143
96.Adolf Hitler Nazi leader Germany 141
97.Shakira Singer Colombia 140
98.Hillary Clinton Ex-President wife USA 140
99.Geena Davis Actress USA 140
100.Jean M. Auel Writer Canada 140
.....
.....
*** IQ munsypedia 115 ( masuk yang ke berapa ya..? )
Mungkin IQ Sobat Juga ada yang lebih tinggi dari mereka,.Ntar ane masukkan ke daftar,...

.jpg)